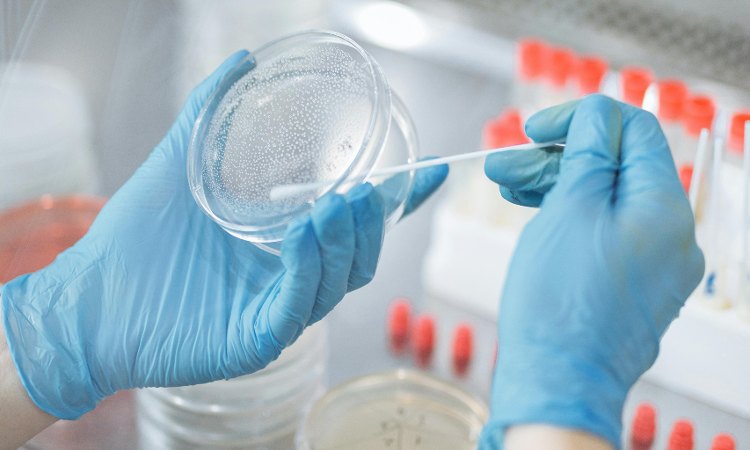

Hlamidija je jedna od najčešćih polno prenosivih infekcija koju uzrokuje bakterija Chlamydia trachomatis.
Iako često prolazi bez simptoma, nelečena hlamidija može dovesti do ozbiljnih zdravstvenih komplikacija, uključujući oštećenje reproduktivnog sistema i povećan rizik od drugih infekcija.
Infekcija se prenosi putem nezaštićenog seksualnog odnosa, a rizične grupe obuhvataju osobe koje imaju više seksualnih partnera ili ne koriste zaštitu.
Zbog asimptomatske prirode bolesti, mnogi ljudi nisu svesni da su zaraženi, što dodatno doprinosi širenju infekcije i njenoj rasprostranjenosti.
U ovom članku ćemo objasniti šta je hlamidija, koji su simptomi, uzroci i načini prenošenja, opcije lečenja i načine prevencije.
Šta je hlamidija?
Hlamidija je bakterijska infekcija do koje dovodi bakterija Chlamydia trachomatis, a danas predstavlja najčešću polno prenosivu infekciju.
Prenosi se tokom nezaštićenog seksualnog odnosa, bilo da je u pitanju vaginalni, analni ili oralni seks.
Hlamidija može zahvatiti različite delove tela, uključujući genitalije, grlić materice, uretru, rektum, a u retkim slučajevima i grlo ili oči.
Jedna od ključnih karakteristika hlamidije je da često ne izaziva simptome, posebno kod žena, što može dovesti do toga da osoba bude zaražena i prenosi infekciju drugima, a da toga nije svesna.
Iz ovog razloga, hlamidija se ponekad naziva tihom infekcijom.
Iako ne izaziva uvek simptome, ako se ne leči može dovesti do ozbiljnih komplikacija.
Kod žena, to uključuje upalu karličnih organa, što može izazvati trajna oštećenja jajovoda i povećati rizik od neplodnosti ili vanmaterične trudnoće.
Kod muškaraca, nelečena infekcija može uzrokovati upalu testisa ili prostate, što može dovesti do bola i, u retkim slučajevima, problema sa plodnošću.
Simptomi
Simptomi hlamidije mogu varirati u zavisnosti od pola i mesta infekcije, a infekcija je često asimptomatska, odnosno bez simptom, što otežava pravoremeno prepoznavanje lečenje infekcije.
Simptomi hlamidije kod žena:
- Neuobičajen vaginalni sekret, koji može biti gust, žućkast ili neprijatnog mirisa
- Bol ili peckanje prilikom mokrenja
- Bol tokom seksualnog odnosa
- Bol u donjem delu stomaka ili karlice
- Krvarenje između menstruacija ili nakon seksualnog odnosa
- Otok, crvenilo ili bol u genitalnom području
Simptomi hlamidije kod muškaraca:
- Pojava iscedka iz penisa, koji može biti bistar, mlečan ili u formi gnoja
- Bol prilikom mokrenja
- Osećaj peckanja ili svraba oko otvora penisa
- Bol u testisima ili oticanje jednog ili oba testisa
- Retko, bol u donjem delu stomaka
Simptomi kod analne infekcije hlamidijom:
- Bol u rektumu
- Iscedak ili krvarenje iz anusa
- Svrab anusa
Simptomi koji se mogu javiti kod oralne infekcije uključuju bol u grlu, ako je infekcija prisutna u grlu, a ponekada može doći i do otečenih limfnih čvorova.
Budući da se simptomi kod hlamidije vrlo često uopšte ne pojavljuju, ili su gotovo neprimetni, redovno testiranje je od velike važnosti kako bi se sprečile potencijalno ozbiljne komplikacije.
Uzroci i načini prenošenja
Hlamidiju izaziva bakterija Chlamydia trachomatis, koja se prenosi uglavnom putem seksualnog kontakta.
Ipak, pitanje da li se hlamidija prenosi samo polnim putem je jedno od najčešćih.
Naime, iako je seksualni odnos najčešći način prenošenja i zaraze, u pitanju je samo jedan od načina.
Postoji nekoliko glavnih načina prenosa ove infekcije:
- Seksualni kontakt: Hlamidija se prenosi tokom vaginalnog, analnog ili oralnog seksualnog odnosa sa zaraženom osobom.
- Kontakt sa telesnim tečnostima: Bakterija se nalazi u zaraženim telesnim tečnostima, poput vaginalnog sekreta, semene tečnosti i rektalnih izlučevina. Direktan kontakt sa ovim tečnostima može izazvati infekciju.
- Prenos sa majke na dete: Trudnice koje imaju hlamidiju mogu preneti infekciju na bebu tokom porođaja, što može uzrokovati ozbiljne zdravstvene probleme kod novorođenčeta, uključujući infekciju očiju, konjunktivitis, ili upalu pluća.
- Korišćenje zaraženih seksualnih igračaka i pomagala: Ako se seksualne igračke i pomagala koriste bez pravilnog čišćenja ili bez kondoma, može doći do prenosa bakterije s jedne osobe na drugu.
Bakterija Chlamydia trachomatis se ne prenosi putem slučajnog fizičkog kontakta, ljubljenja, grljenja, zajedničkog korišćenja toaleta, bazena ili deljenja posuđa i pribora.
Određeni faktori povećavaju rizik od infekcije hlamidijom, uključujući:
- Nezaštićene seksualne odnose
- Česte promene seksualnih partnera
- Rana seksualna aktivnost
- Infekcije u prošlosti
- Trudnoća
Dijagnoza
Dijagnoza hlamidije se postavlja na osnovu laboratorijskih testova. Testovi koji se koriste za otkrivanje hlamidije uključuju uzorke urina ili briseve iz genitalnih oblasti.
Kod žena se obično uzima bris grlića materice ili vagine, dok se kod muškaraca uzima bris iz mokraćne cevi.
U nekim slučajevima, posebno ako postoji sumnja na analnu ili oralnu infekciju, uzimaju se i brisevi iz rektuma ili grla.
Preporučuje se da se svi seksualno aktivni pojedinci, posebno oni mlađi od 25 godina ili osobe koje imaju više partnera, redovno testiraju na hlamidiju i druge polno prenosive infekcije.
Kao što je ranije objašnjeno, hlamidija često ne izaziva simptome, zbog čega je redovno preventivno testiranje od ključne važnosti za rano otkrivanje i lečenje infekcije.
Takođe, za osobe koje su pod povećanim rizikom, povišene vrednosti leukocita u urinu mogu biti znak da su potrebne detaljnije dijagnostičke procedure.
Lečenje
Lečenje hlamidije se u najvećem broju slučajeva bazira na primeni antibiotika, a najčešće se koriste azitromicin ili doksiciklin.
Azitromicin se obično daje u jednoj dozi, dok se doksiciklin uzima dva puta dnevno tokom sedam dana.
Drugi antibiotici, poput eritromicina, ofloksacina ili levofloksacina, mogu se prepisati u slučaju alergije ili drugih medicinskih razloga.
Terapija antibioticima je izuzetno efikasna, ali je važno napomenuti da pravilno uzimanje lekova igra ključnu ulogu u potpunom izlečenju.
Prekid terapije ili nepridržavanje načina uzimanja antibiotika može dovesti do ponovne pojave infekcije ili razvoja otpornosti na lekove.
Antibiotike nikada ne treba uzimati samoinicijativno, čak ni kod potvrđene infekcije, već isključivo onda kada je to prepisano od strane lekara, i na način na koji je prepisano.
Tokom lečenja antibioticima savetuje se upotreba probiotika, kako bi se očuvale korisne bakterije i smanjile moguće nuspojave antibiotika, poput mučnine, dijareje i drugih probavnih tegoba.
Tokom lečenja hlamidije, izuzetno je važno izbegavati seksualne odnose, kako bi se sprečilo dalje širenje infekcije.
Takođe, preporučuje se da se svi seksualni partneri testiraju i leče, kako bi se izbegla reinfekcija.
Nakon završetka terapije, neophodno je uraditi kontrolni test kako bi se potvrdilo da je infekcija uspešno eliminisana.
Ignorisanje simptoma ili odlaganje lečenja može dovesti do ozbiljnih komplikacija.
Rizik od ponovne infekcije
Uprkos efikasnosti lečenja, rizik od ponovne infekcije hlamidijom postoji čak i nakon uspešnog lečenja.
To se najčešće događa kada seksualni partner nije adekvatno lečen ili ako se nastave nezaštićeni seksualni odnosi sa zaraženom osobom.
Zbog toga je važno da se svi seksualni partneri testiraju i leče istovremeno kako bi se izbegla reinfekcija.
Takođe, korišćenje zaštite, poput kondoma, i redovno testiranje su ključne mere za sprečavanje ponovne infekcije.
Ponovna infekcija može dodatno povećati rizik od ozbiljnih komplikacija, uključujući neplodnost i druge dugotrajne probleme sa reproduktivnim zdravljem.
Komplikacije
Nelečena hlamidija može dovesti do ozbiljnih komplikacija, posebno ako infekcija traje duže vreme bez adekvatnog lečenja.
Ove komplikacije mogu značajno uticati na reproduktivno zdravlje i kvalitet života.
Kod žena, nelečena hlamidija može izazvati:
- Upalnu bolest karlice: Hlamidija se može proširiti na matericu, jajnike i jajovode, što dovodi do upale. Upalna bolest karlice može izazvati dugotrajne bolove u karlici, ožiljke na jajovodima i povećavan rizik od vanmaterične trudnoće i neplodnosti.
- Neplodnost: Oštećenja na jajovodima zbog infekcije mogu dovesti do trajnih problema sa plodnošću, sprečavajući oplodnju ili normalan prolazak oplođene jajne ćelije.
- Komplikacije u trudnoći: Hlamidija u trudnoći može izazvati prerani porođaj ili infekcije kod novorođenčadi, poput upale pluća ili konjunktivitisa.
Kod muškaraca, nelečena hlamidija može izazvati:
- Epididimitis: Upala epididimisa, kanala kroz koji prolaze spermatozoidi, može izazvati bol i otok u testisima. U teškim slučajevima, može dovesti do neplodnosti.
- Reaktivni artritis: Hlamidija može izazvati autoimunu reakciju koja uzrokuje bolove i otok u zglobovima, a ponekad i očima i koži. Ova komplikacija se javlja kod oba pola.
- Prostatitis: Hlamidija može izazvati upalu prostate, što dovodi do bolova prilikom mokrenja, nelagodnosti u donjem delu leđa i problema sa erekcijom.
Ako se infekcija proširi na druge delove tela, poput rektuma ili očiju, mogu se javiti dodatne komplikacije.
Prevencija
Prevencija hlamidije prvenstveno podrazumeva odgovorno ponašanje u vezi sa seksualnim odnosima, redovne zdravstvene kontrole i edukaciju o načinima prenosa infekcije.
Jedan od najefikasnijih načina sprečavanja infekcije je korišćenje kondoma tokom svakog seksualnog odnosa, bilo da je u pitanju vaginalni, analni ili oralni.
Kondomi su najefikasniji zahvaljujući činjenici da pružaju fizičku barijeru koja smanjuje rizik od prenosa bakterije.
Takođe, uzdržavanje od nezaštićenih seksualnih odnosa sa više partnera i održavanje veze sa samo jednim partnerom koji je testiran na polno prenosive bolesti može značajno smanjiti rizik od infekcije.
Redovni zdravstveni pregledi, posebno kod osoba koje su seksualno aktivne, su od velikog značaja, jer hlamidija često ne izaziva simptome, pa dugo može ostati neotkrivena.
Kao što je prethodno objašnjeno, rano otkrivanje i lečenje infekcije sprečavaju njeno širenje i potencijalne komplikacije.
Edukacija o tome kako se prenosi hlamidija je važna, budući da se često smatra da se infekcija može preneti isključivo seksualnim odnosom.
Uprkos tome što je glavni način prenosa polni odnos, važno je znati sve potencijalne puteve prenosa kako bi se smanjio rizik od infekcije.
Pored hlamidije, praktikovanjem nezaštićenih seksualnih odnosa povećava se rizik od drugih polno prenosivih bolesti, kao što su gonoreja, sifilis, herpes, HIV, i HPV.
Hlamidija u trudnoći
Hlamidija u trudnoći može biti ozbiljna jer može dovesti do komplikacija kako za majku, tako i za bebu.
Ako se ne leči, hlamidija može izazvati infekcije koje mogu dovesti do ranog porođaja, pucanja vodenjaka, pa čak i niske porođajne težine bebe.
Takođe, hlamidija može da se prenese sa majke na bebu tokom porođaja, što može dovesti do infekcije očiju ili upale pluća kod novorođenčeta.
Iako ove komplikacije mogu biti ozbiljne, mogu se uspešno lečiti ako se otkriju na vreme.
Zbog tih rizika, trudnicama se preporučuje da urade test na hlamidiju u ranoj fazi trudnoće, posebno ako su u grupi sa povećanim rizikom.
Lečenje tokom trudnoće je bezbedno i obično uključuje antibiotike koji su sigurni za trudnice, a pravovremeno lečenje značajno smanjuje rizik od komplikacija po majku i bebu.
Zaključak
Hlamidija je ozbiljna polno prenosiva infekcija koja često prolazi bez simptoma, ali može dovesti do ozbiljnih zdravstvenih komplikacija ako se ne leči na vreme.
Kada izaziva simptome, oni se blago razliku u zavisnosti od pola, ali obično uključuju bol ili peckanje tokom mokrenja, bol u donjem delu stomaka, pojavu sekreta i druge.
Rano prepoznavanje, redovno testiranje i odgovarajuće lečenje antibioticima ključni su za sprečavanje trajnih oštećenja reproduktivnih organa, posebno kod žena, kada može uzrokovati neplodnost ili komplikacije u trudnoći.
Redovna upotreba zaštite i pravovremena dijagnostika ključni su za smanjenje rizika od infekcije i komplikacija.